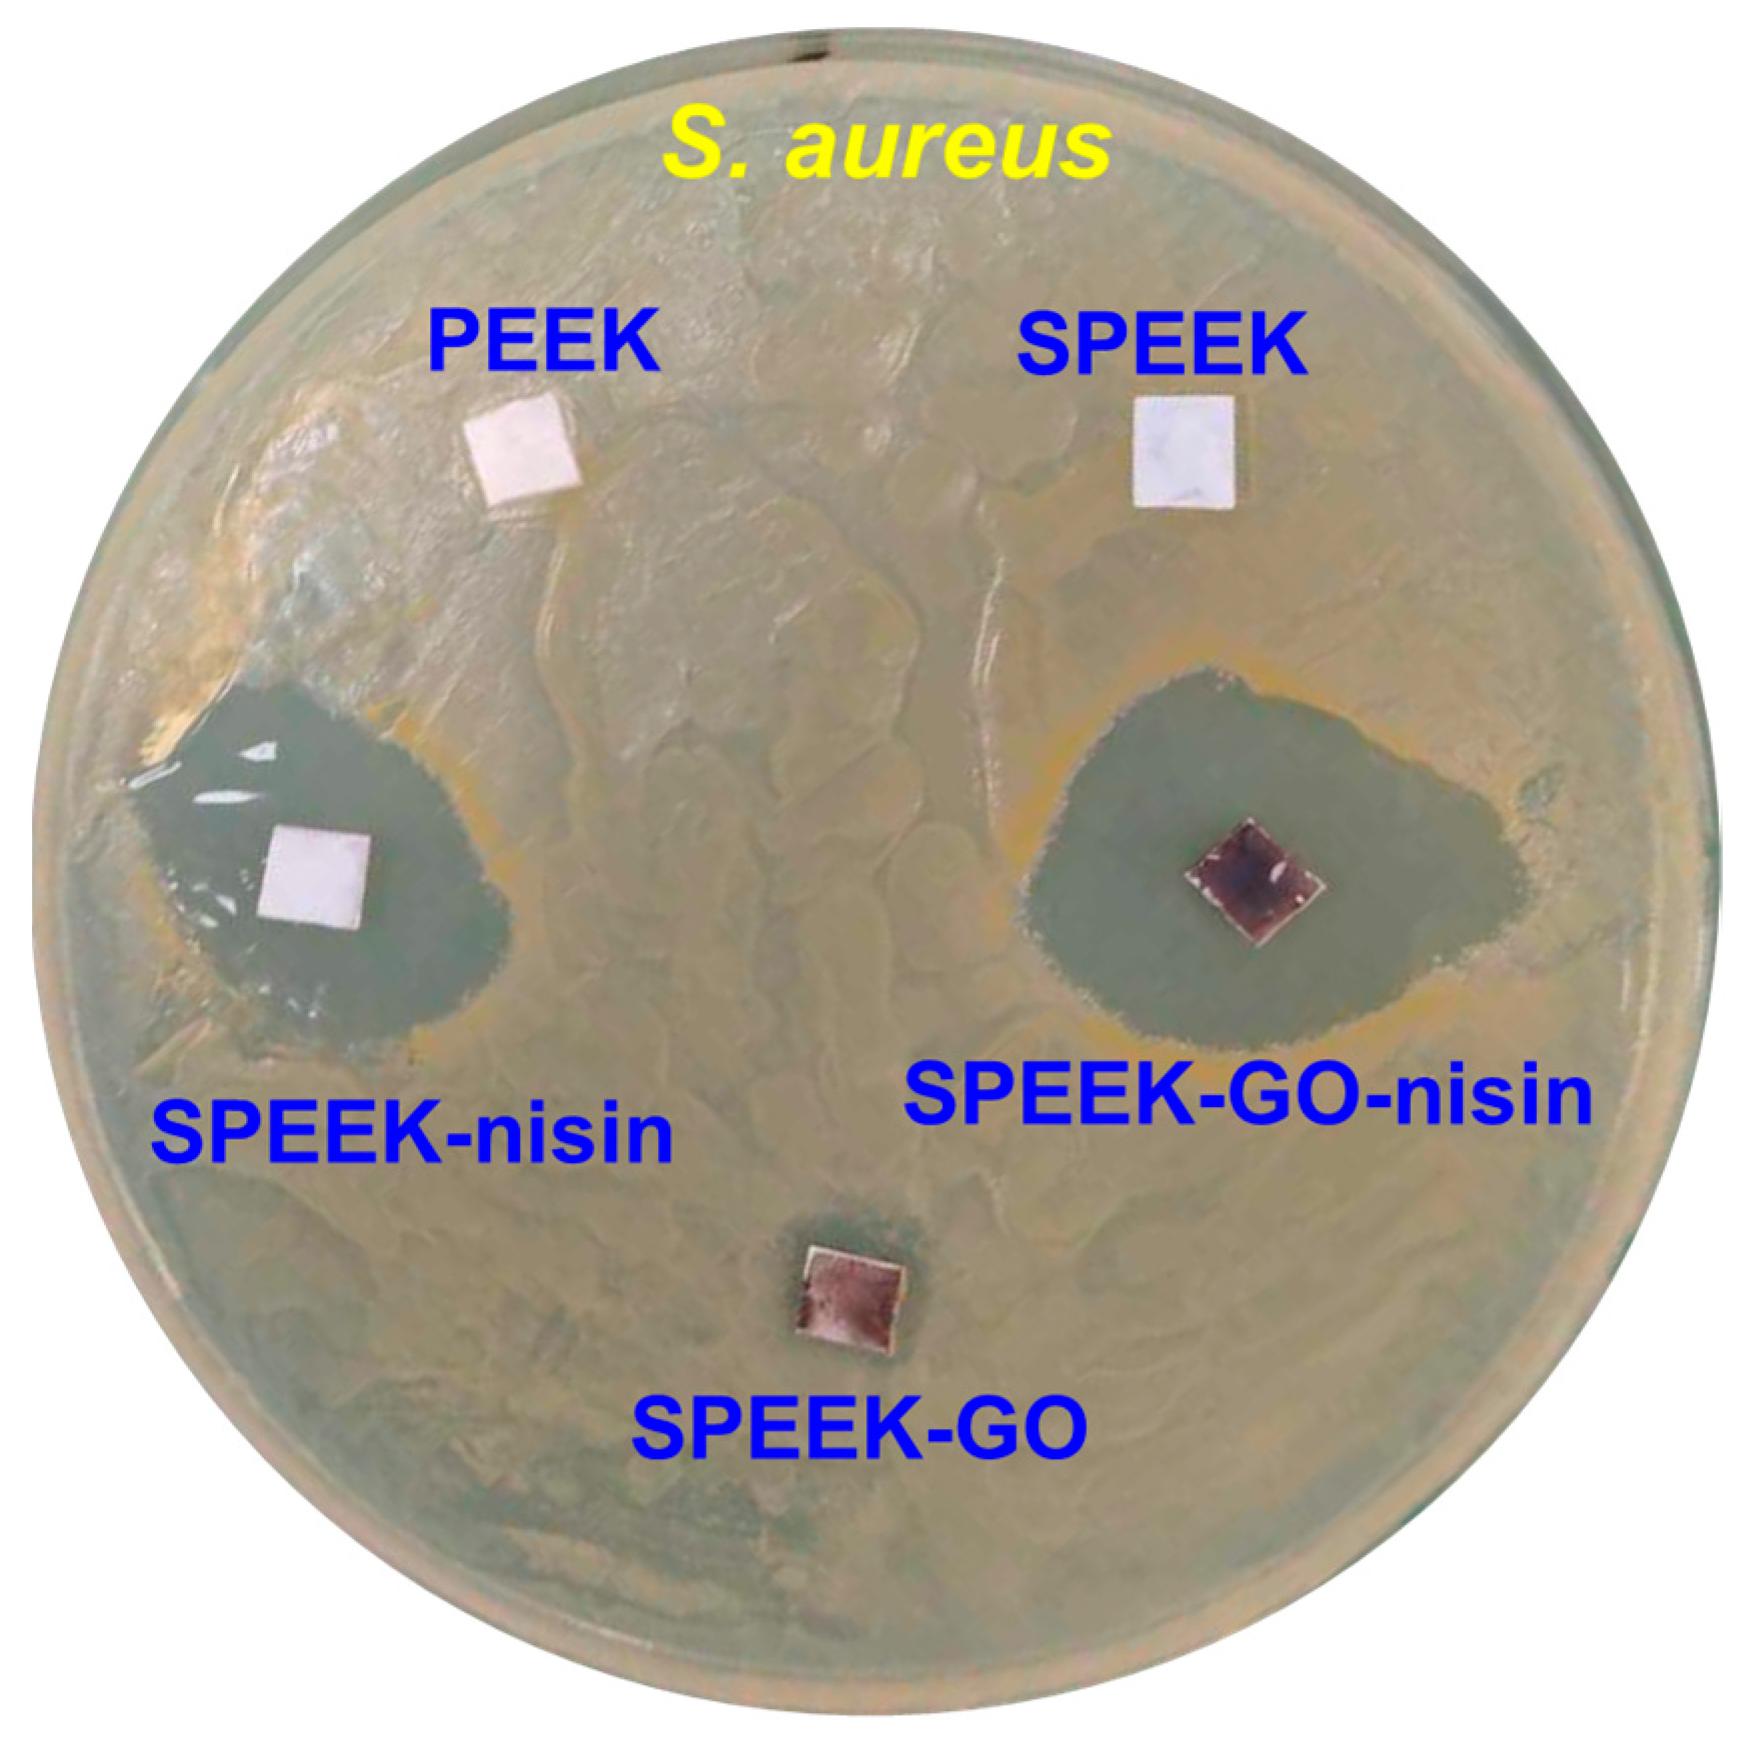
Antibiotics 12 01407 g006

Antimicrobial Peptide Conjugated on Graphene Oxide-Containing Sulfonated Polyetheretherketone Substrate for Effective Antibacterial Activities against Staphylococcus aureus
Abstract
:1. Introduction
2. Results and Discussion
2.1. Surface Morphological Analysis
2.2. Structural and Contact Angle Studies
2.3. Antibacterial Activities against S. aureus Bacteria
2.4. Bacteria Adhered on Samples
3. Materials and Methods
3.1. Preparation of Sulfonated PEEK
3.2. Preparation of SPEEK-GO Sample
3.3. Antimicrobial Peptide of Nisin Conjugated SPEEK-GO
3.4. Characterizations of Composite Samples
3.5. Antibacterial Analysis Using an Agar Diffusion Assay
4. Conclusions
Supplementary Materials
Author Contributions
Funding
Institutional Review Board Statement
Informed Consent Statement
Data Availability Statement
Conflicts of Interest
References
- Balali, G.I.; Yar, D.D.; Afua Dela, V.G.; Adjei-Kusi, P. Microbial contamination, an increasing threat to the consumption of fresh fruits and vegetables in today’s world. Inter. J. Microbiol. 2020, 2020, 3029295. [Google Scholar]
- Alegbeleye, O.O.; Singleton, I.; Sant’Ana, A.S. Sources and contamination routes of microbial pathogens to fresh produce during field cultivation: A review. Food Microbiol. 2018, 73, 177–208. [Google Scholar] [PubMed]
- Breijyeh, Z.; Karaman, R. Design and synthesis of novel antimicrobial agents. Antibiotics 2023, 12, 628. [Google Scholar] [PubMed]
- Chinemerem Nwobodo, D.; Ugwu, M.C.; Oliseloke Anie, C.; Al-Ouqaili, M.T.S.; Chinedu Ikem, J.; Victor Chigozie, U.; Saki, M. Antibiotic resistance: The challenges and some emerging strategies for tackling a global menace. J. Clin. Lab. Anal. 2022, 36, e24655. [Google Scholar]
- Aveyard, J.; Bradley, J.W.; McKay, K.; McBride, F.; Donaghy, D.; Raval, R.; D’Sa, R.A. Linker-free covalent immobilization of nisin using atmospheric pressure plasma induced grafting. J. Mater. Chem. B 2017, 5, 2500–2510. [Google Scholar]
- Jiang, L.; Su, C.; Wen, Y.; Zhu, Z.; Liu, J.; He, S.; He, S.; Liu, X.; Shao, W. Antibacterial activity and long-term stable antibacterial performance of nisin grafted magnetic GO nanohybrids. Mater. Sci. Eng. C 2020, 111, 110809. [Google Scholar]
- Li, G.; Lai, Z.; Shan, A. Advances of antimicrobial peptide-based biomaterials for the treatment of bacterial infections. Adv. Sci. 2023, 10, 2206602. [Google Scholar]
- Liu, D.; Xi, Y.; Yu, S.; Yang, K.; Zhang, F.; Yang, Y.; Wang, T.; He, S.; Zhu, Y.; Fan, Z.; et al. A polypeptide coating for preventing biofilm on implants by inhibiting antibiotic resistance genes. Biomaterials 2023, 293, 121957. [Google Scholar]
- Naaz, T.; Lahiri, D.; Pandit, S.; Nag, M.; Gupta, P.K.; Al-Dayan, N.; Rai, N.; Chaubey, K.K.; Gupta, A.K. Antimicrobial peptides against microbial biofilms: Efficacy, challenges, and future prospect. Int. J. Pept. Res. Ther. 2023, 29, 48. [Google Scholar]
- Haleem, A.; Javaid, M. Polyether ether ketone (PEEK) and its 3D printed implants applications in medical field: An overview. Clin. Epidemiol. Glob. Health 2019, 7, 571–577. [Google Scholar]
- Ma, R.; Tang, T. Current strategies to improve the bioactivity of PEEK. Int. J. Mol. Sci. 2014, 15, 5426–5445. [Google Scholar] [CrossRef] [PubMed]
- Liu, L.; Zhang, W.; Yuan, L.; Liu, Y.; Zheng, Y. Ameliorative antibacterial, anti-inflammatory, and osteogenic activity of sulfonate-bearing polyetheretherketone toward orthopedic and dental implants. Mater. Lett. 2021, 305, 130774. [Google Scholar] [CrossRef]
- Rendas, P.; Figueiredo, L.; Machado, C.; Mourão, A.; Vidal, C.; Soares, B. Mechanical performance and bioactivation of 3D-printed PEEK for high-performance implant manufacture: A review. Prog. Biomater. 2022, 12, 89–111. [Google Scholar] [PubMed]
- Li, X.; Zenobi, R. Use of polyetheretherketone as a material for solid phase extraction of hydroxylated metabolites of polycyclic aromatic hydrocarbons in human urine. Anal. Chem. 2013, 85, 3526–3531. [Google Scholar] [CrossRef]
- Zheng, Y.; Liu, L.; Xiong, C.; Zhang, L. Enhancement of bioactivity on modified polyetheretherketone surfaces with –COOH, –OH and –PO4H2 functional groups. Mater. Lett. 2018, 213, 84–87. [Google Scholar] [CrossRef]
- Han, X.; Gao, W.; Zhou, Z.; Yang, S.; Wang, J.; Shi, R.; Li, Y.; Jiao, J.; Qi, Y.; Zhao, J. Application of biomolecules modification strategies on PEEK and its composites for osteogenesis and antibacterial properties. Col. Surf. B Biointerfaces 2022, 215, 112492. [Google Scholar]
- AlOtaibi, N.; Naudi, K.; Conway, D.; Ayoub, A. The current state of peek implant osseointergration and future perspectives: A systematic review. Eur. Cells Mater. 2020, 40, 1–20. [Google Scholar] [CrossRef]
- Chen, Z.; Chen, Y.; Ding, J.; Yu, L. Blending strategy to modify PEEK-based orthopedic implants. Comp. Part B Eng. 2023, 250, 110427. [Google Scholar]
- Jančič, U.; Gorgieva, S. Bromelain and nisin: The natural antimicrobials with high potential in biomedicine. Pharmaceutics 2022, 14, 76. [Google Scholar] [CrossRef]
- Shin, J.M.; Gwak, J.W.; Kamarajan, P.; Fenno, J.C.; Rickard, A.H.; Kapila, Y.L. Biomedical applications of nisin. J. Appl. Microbiol. 2016, 120, 1449–1465. [Google Scholar] [CrossRef]
- Pandey, P.; Hansmann, U.H.E.; Wang, F. Altering the solubility of the antibiotic candidate nisin—A computational study. ACS Omega 2020, 5, 24854–24863. [Google Scholar] [CrossRef] [PubMed]
- Hsu, S.-T.D.; Breukink, E.; Tischenko, E.; Lutters, M.A.; De Kruijff, B.; Kaptein, R.; Bonvin, A.M.; Van Nuland, N.A. The nisin–lipid II complex reveals a pyrophosphate cage that provides a blueprint for novel antibiotics. Nat. Struct. Mol. Biol. 2004, 11, 963–967. [Google Scholar] [CrossRef] [PubMed]
- de Oliveira Junior, A.A.; Silva de Araújo Couto, H.G.; Barbosa, A.A.T.; Carnelossi, M.A.G.; de Moura, T.R. Stability, antimicrobial activity, and effect of nisin on the physico-chemical properties of fruit juices. Int. J. Food Microbiol. 2015, 211, 38–43. [Google Scholar] [CrossRef]
- Jensen, C.; Li, H.; Vestergaard, M.; Dalsgaard, A.; Frees, D.; Leisner, J.J. Nisin damages the septal membrane and triggers DNA condensation in methicillin-resistant Staphylococcus aureus. Front. Microbiol. 2020, 11, 1007. [Google Scholar] [CrossRef] [PubMed]
- Zhao, X.; Meng, R.; Shi, C.; Liu, Z.; Huang, Y.; Zhao, Z.; Guo, N.; Yu, L. Analysis of the gene expression profile of Staphylococcus aureus treated with nisin. Food Control 2016, 59, 499–506. [Google Scholar] [CrossRef]
- Hu, C.-C.; Kumar, S.R.; Vi, T.T.T.; Huang, Y.-T.; Chen, D.W.; Lue, S.J. Facilitating GL13K Peptide Grafting on Polyetheretherketone via 1-Ethyl-3-(3-dimethylaminopropyl)carbodiimide: Surface Properties and Antibacterial Activity. Int. J. Mol. Sci. 2022, 23, 359. [Google Scholar] [CrossRef]
- Ha, S.-W.; Hauert, R.; Ernst, K.-H.; Wintermantel, E. Surface analysis of chemically-etched and plasma-treated polyetheretherketone (PEEK) for biomedical applications. Surf. Coat. Technol. 1997, 96, 293–299. [Google Scholar] [CrossRef]
- Stawarczyk, B.; Jordan, P.; Schmidlin, P.R.; Roos, M.; Eichberger, M.; Gernet, W.; Keul, C. PEEK surface treatment effects on tensile bond strength to veneering resins. J. Prosthet. Dent. 2014, 112, 1278–1288. [Google Scholar] [CrossRef]
- Ouyang, L.; Deng, Y.; Yang, L.; Shi, X.; Dong, T.; Tai, Y.; Yang, W.; Chen, Z.G. Graphene-oxide-decorated microporous polyetheretherketone with superior antibacterial capability and in vitro osteogenesis for orthopedic implant. Macromol. Biosci. 2018, 18, 1800036. [Google Scholar] [CrossRef]
- He, M.; Chen, X.; Guo, Z.; Qiu, X.; Yang, Y.; Su, C.; Jiang, N.; Li, Y.; Sun, D.; Zhang, L. Super tough graphene oxide reinforced polyetheretherketone for potential hard tissue repair applications. Comp. Sci. Tech. 2019, 174, 194–201. [Google Scholar] [CrossRef]
- Guo, C.; Lu, R.; Wang, X.; Chen, S. Antibacterial activity, bio-compatibility and osteogenic differentiation of graphene oxide coating on 3D-network poly-ether-ether-ketone for orthopaedic implants. J. Mater. Sci. Mater. Med. 2021, 32, 135. [Google Scholar] [CrossRef] [PubMed]
- Kanchanapally, R.; Viraka Nellore, B.P.; Sinha, S.S.; Pedraza, F.; Jones, S.J.; Pramanik, A.; Chavva, S.R.; Tchounwou, C.; Shi, Y.; Vangara, A.; et al. Antimicrobial peptide-conjugated graphene oxide membrane for efficient removal and effective killing of multiple drug resistant bacteria. RSC Adv. 2015, 5, 18881–18887. [Google Scholar] [CrossRef]
- Yang, X.; Chai, H.; Guo, L.; Jiang, Y.; Xu, L.; Huang, W.; Shen, Y.; Yu, L.; Liu, Y.; Liu, J. In situ preparation of porous metal-organic frameworks ZIF-8@Ag on poly-ether-ether-ketone with synergistic antibacterial activity. Coll. Surf. B Biointerfaces 2021, 205, 111920. [Google Scholar] [CrossRef] [PubMed]
- Gao, C.; Wang, Z.; Jiao, Z.; Wu, Z.; Guo, M.; Wang, Y.; Liu, J.; Zhang, P. Enhancing antibacterial capability and osseointegration of polyetheretherketone (PEEK) implants by dual-functional surface modification. Mater. Des. 2021, 205, 109733. [Google Scholar] [CrossRef]
- Song, J.; Liao, Z.; Shi, H.; Xiang, D.; Liu, Y.; Liu, W.; Peng, Z. Fretting wear study of PEEK-based composites for bio-implant application. Tribol. Lett. 2017, 65, 150. [Google Scholar] [CrossRef]
- Gaitanelis, D.; Chanteli, A.; Worrall, C.; Weaver, P.M.; Kazilas, M. A multi-technique and multi-scale analysis of the thermal degradation of PEEK in laser heating. Polym. Degrad. Stab. 2023, 211, 110282. [Google Scholar] [CrossRef]
- Przykaza, K.; Jurak, M.; Kalisz, G.; Mroczka, R.; Wiącek, A.E. Characteristics of hybrid bioglass-chitosan coatings on the plasma activated PEEK polymer. Molecules 2023, 28, 1729. [Google Scholar] [CrossRef]
- Cheng, B.; Duan, H.; Chen, Q.; Shang, H.; Zhang, Y.; Li, J.; Shao, T. Effect of laser treatment on the tribological performance of polyetheretherketone (PEEK) under seawater lubrication. App. Surf. Sci. 2021, 566, 150668. [Google Scholar] [CrossRef]
- Hu, Y.; Wu, T.; Wu, C.; Fu, S.; Yuan, C.; Chen, S. Formation and optimization of chitosan-nisin microcapsules and its characterization for antibacterial activity. Food Control 2017, 72, 43–52. [Google Scholar] [CrossRef]
- Krivorotova, T.; Cirkovas, A.; Maciulyte, S.; Staneviciene, R.; Budriene, S.; Serviene, E.; Sereikaite, J. Nisin-loaded pectin nanoparticles for food preservation. Food Hydrocoll. 2016, 54, 49–56. [Google Scholar] [CrossRef]
- Jiang, S.; Wang, H.; Chu, C.; Ma, X.; Sun, M.; Jiang, S. Synthesis of antimicrobial Nisin-phosphorylated soybean protein isolate/poly (l-lactic acid)/ZrO2 membranes. Int. J. Biol. Macromol. 2015, 72, 502–509. [Google Scholar] [CrossRef]
- Joshi, S.; Sharma, P.; Siddiqui, R.; Kaushal, K.; Sharma, S.; Verma, G.; Saini, A. A review on peptide functionalized graphene derivatives as nanotools for biosensing. Microchim. Acta 2019, 187, 27. [Google Scholar] [CrossRef] [PubMed]
- Truong, T.T.V.; Chen, C.-C.; Kumar, S.R.; Hu, C.-C.; Chen, D.W.; Liu, Y.-K.; Lue, S.J. Prismatic silver nanoparticles decorated on graphene oxide sheets for superior antibacterial activity. Pharmaceutics 2022, 14, 924. [Google Scholar] [CrossRef] [PubMed]
- Vi, T.T.T.; Kumar, S.R.; Pang, J.-H.S.; Liu, Y.-K.; Chen, D.W.; Lue, S.J. Synergistic antibacterial activity of silver-loaded graphene oxide towards Staphylococcus aureus and Escherichia coli. Nanomaterials 2020, 10, 366. [Google Scholar] [CrossRef] [PubMed]
- Prince, A.; Sandhu, P.; Ror, P.; Dash, E.; Sharma, S.; Arakha, M.; Jha, S.; Akhter, Y.; Saleem, M. Lipid-II independent antimicrobial mechanism of nisin depends on its crowding and degree of oligomerization. Sci. Rep. 2016, 6, 37908. [Google Scholar] [CrossRef] [PubMed]
- Wang, P.; Wang, H.; Zhao, X.; Li, L.; Chen, M.; Cheng, J.; Liu, J.; Li, X. Antibacterial activity and cytotoxicity of novel silkworm-like nisin@PEGylated MoS2. Colloids Surf. B Biointerfaces 2019, 183, 110491. [Google Scholar] [CrossRef]
- Behzadi, F.; Darouie, S.; Alavi, S.M.; Shariati, P.; Singh, G.; Dolatshahi-Pirouz, A.; Arpanaei, A. Stability and antimicrobial activity of nisin-loaded mesoporous silica nanoparticles: A game-changer in the war against maleficent microbes. J. Agric. Food Chem. 2018, 66, 4233–4243. [Google Scholar] [CrossRef]
- Xu, X.; Jin, T.; Zhang, B.; Liu, H.; Ye, Z.; Xu, Q.; Chen, H.; Wang, B. In vitro and in vivo evaluation of the antibacterial properties of a nisin-grafted hydrated mucin multilayer film. Polym. Test. 2017, 57, 270–280. [Google Scholar] [CrossRef]
- Sadraei, F.; Ghollasi, M.; Khakpai, F.; Halabian, R.; Jalali Tehrani, H. Osteogenic differentiation of pre-conditioned bone marrow mesenchymal stem cells with Nisin on modified poly-L-lactic-acid nanofibers. Regen. Ther. 2022, 21, 263–270. [Google Scholar] [CrossRef]

Disclaimer/Publisher’s Note: The statements, opinions and data contained in all publications are solely those of the individual author(s) and contributor(s) and not of MDPI and/or the editor(s). MDPI and/or the editor(s) disclaim responsibility for any injury to people or property resulting from any ideas, methods, instructions or products referred to in the content. |
© 2023 by the authors. Licensee MDPI, Basel, Switzerland. This article is an open access article distributed under the terms and conditions of the Creative Commons Attribution (CC BY) license (https://creativecommons.org/licenses/by/4.0/).
Share and Cite
Kumar, S.R.; Hu, C.-C.; Vi, T.T.T.; Chen, D.W.; Lue, S.J. Antimicrobial Peptide Conjugated on Graphene Oxide-Containing Sulfonated Polyetheretherketone Substrate for Effective Antibacterial Activities against Staphylococcus aureus. Antibiotics 2023, 12, 1407. https://doi.org/10.3390/antibiotics12091407
Kumar SR, Hu C-C, Vi TTT, Chen DW, Lue SJ. Antimicrobial Peptide Conjugated on Graphene Oxide-Containing Sulfonated Polyetheretherketone Substrate for Effective Antibacterial Activities against Staphylococcus aureus. Antibiotics. 2023; 12(9):1407. https://doi.org/10.3390/antibiotics12091407
Chicago/Turabian StyleKumar, Selvaraj Rajesh, Chih-Chien Hu, Truong Thi Tuong Vi, Dave W. Chen, and Shingjiang Jessie Lue. 2023. "Antimicrobial Peptide Conjugated on Graphene Oxide-Containing Sulfonated Polyetheretherketone Substrate for Effective Antibacterial Activities against Staphylococcus aureus" Antibiotics 12, no. 9: 1407. https://doi.org/10.3390/antibiotics12091407
APA StyleKumar, S. R., Hu, C.-C., Vi, T. T. T., Chen, D. W., & Lue, S. J. (2023). Antimicrobial Peptide Conjugated on Graphene Oxide-Containing Sulfonated Polyetheretherketone Substrate for Effective Antibacterial Activities against Staphylococcus aureus. Antibiotics, 12(9), 1407. https://doi.org/10.3390/antibiotics12091407

